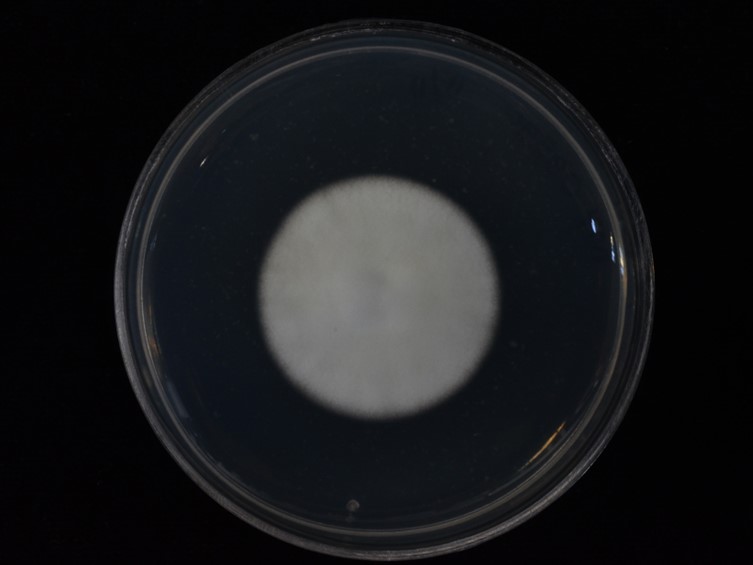

Holotype:
THAILAND, Nakhon Ratchasima Province, Khao Yai National Park, 6 Jun. 2014, W. Noisripoom, T. Chohmee, P. Srikitikulchai, S. Sommai, R. Somnuk, holotype BBH 38669, ex-type living culture BCC 72638.
Habitat:
Underside of leaf.
Host:
Adult moths (Tortricidae; Lepidoptera).
Description:
Specimens examined in this study can be found on the underside of dicotyledonous leaves and palm leaf. The hosts were adult moths, ca 4-9 × 1-2 mm. Two types of  synnemata were produced on insect hosts. Several long synnemata arose at the head and in the middle of the host body, white to cream, up to 5 mm long and ca 120-150 μm wide, rarely branched, cylindrical to clavate with acute or blunt end. Conidiogenous cells produced along synnemata, monophialidic or polyphialidic.
synnemata were produced on insect hosts. Several long synnemata arose at the head and in the middle of the host body, white to cream, up to 5 mm long and ca 120-150 μm wide, rarely branched, cylindrical to clavate with acute or blunt end. Conidiogenous cells produced along synnemata, monophialidic or polyphialidic.  Phialides 5-10 × 1.8-3 μm, cylindrical to ellipsoidal with papillate end.
Phialides 5-10 × 1.8-3 μm, cylindrical to ellipsoidal with papillate end.  Conidia smooth-walled, hyaline, single-celled, fusoid, 2-3.2 × 0.8-2 μm. Several short synnemata arose on moth body, wings, and legs, white to cream, 197-300 × 15-40 μm, with diam of the tip 43-75 μm, cylindrical with subglobose or oblong end. Conidiogenous cells produced at the end of synnemata, monophialidic or polyphialidic. Phialides 5-10 × 1.8-3 μm, cylindrical to ellipsoidal with papillate end. Conidia smooth-walled, hyaline, single-celled, fusoid, 1-3 × 1-2 μm. Phialides and conidia from both long and short synnemata were on the same size range.
Conidia smooth-walled, hyaline, single-celled, fusoid, 2-3.2 × 0.8-2 μm. Several short synnemata arose on moth body, wings, and legs, white to cream, 197-300 × 15-40 μm, with diam of the tip 43-75 μm, cylindrical with subglobose or oblong end. Conidiogenous cells produced at the end of synnemata, monophialidic or polyphialidic. Phialides 5-10 × 1.8-3 μm, cylindrical to ellipsoidal with papillate end. Conidia smooth-walled, hyaline, single-celled, fusoid, 1-3 × 1-2 μm. Phialides and conidia from both long and short synnemata were on the same size range.
Culture characteristics:
Colony on PDA growing with a diam of 25–31 mm in 14 d, white, circular, flat, entire, reverse pale yellow. Mycelium smooth, septate, hyaline. Conidia and reproductive structures not produced.
Colony on PDA growing with a diam of 25–31 mm in 14 d, white, circular, flat, entire, reverse pale yellow. Mycelium smooth, septate, hyaline. Conidia and reproductive structures not produced.
Reference:
Aini AN, Mongkolsamrit S, Wijanarka W, et al. (2020). Diversity of Akanthomyces on moths (Lepidoptera) in Thailand. MycoKeys 71: 1–22.
DOI: http://doi.org/10.3897/mycokeys.71.55126Species |
Strain |
Compound |
Pubchem CID |
Biological activity |
Reference |
|---|
|
Strain |
ITS | LSU | RPB1 | RPB2 | TEF1 |
|---|---|---|---|---|---|
| BCC 28583 | MT356079 | MT356090 | MT477999 | MT477993 | MT477986 |
| BCC 41868 | MT 356077 | MT356089 | MT477998 | MT478008 | MT477985 |
| BCC 72638 | MT356076 | MT356088 | MT477997 | MT477992 | MT478004 |